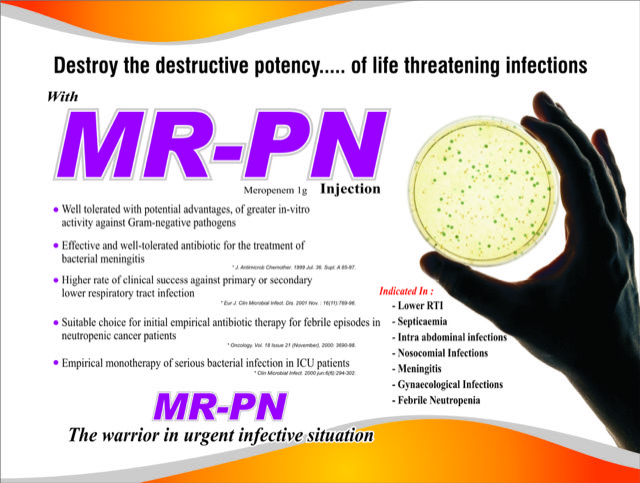

Paeon Pharmaceutical was envisioned by a group of diverse professionals with an objective to make pharmaceutical products accessible to all, at affordable costs, while maintaining standards in sync with highest global quality benchmarks. Rolex Replica
Paeon Pharmaceutical is actively involved in pharmaceutical manufacturing and marketing with operations focused on North Indian states. We have exclusive tie ups with marquee channel partners who manufacture our products aimed to provide quality pharmaceuticals formulations. replica bags
learn moretext.

Amoxapen 625 Amoxycillin 500 mg+Potassium Clavulanate 125 mg.

Cal-PN 12 Calcitriol 0.25 mcg, Calcium Carbonate 500 mg & Zinc 7.5 mg .

Cefio-PN Cefixime 200 mg+ Ofloxacin 200 mg.

CS-PN Ccftriaxone 1 g + Sulbactum 0.5 g.

Cholecalciferol Drops 30 ml 18 12 CS-PN Ccftriaxone 1 g + Sulbactum 0.5 g.

Dextromethorphan 5mg + Phenylephrin 5mg + CPM 2mg.

Methylcobalamin 1500 mcg.+ Alpha Lipoic acid 100 mg +Folic Acid 1.5 mg+ Thiamine Mononitrate 10 mg. + Pyridoxin Hydrochloride 3 mg.

Prebiotic & Probiotich 18.

Aceclofenace 100 mg+Paracetamole 325 mg + Serrtiopeptidase 15 in t2.
Meropenam.

Alpha-Beta Arteether (75 mg per ml).

Pantoprazole 40 mg+ Domperidone 30 mg.

Ferrous Ascorbate 30mg + Folic Acid 1.5mg+Zinc 22.5 mg .

Cefpodoxime 50 mg (Dry Syrup).

Lever Syrup (Ayurvedic).

MultiVitamine with Lysine.